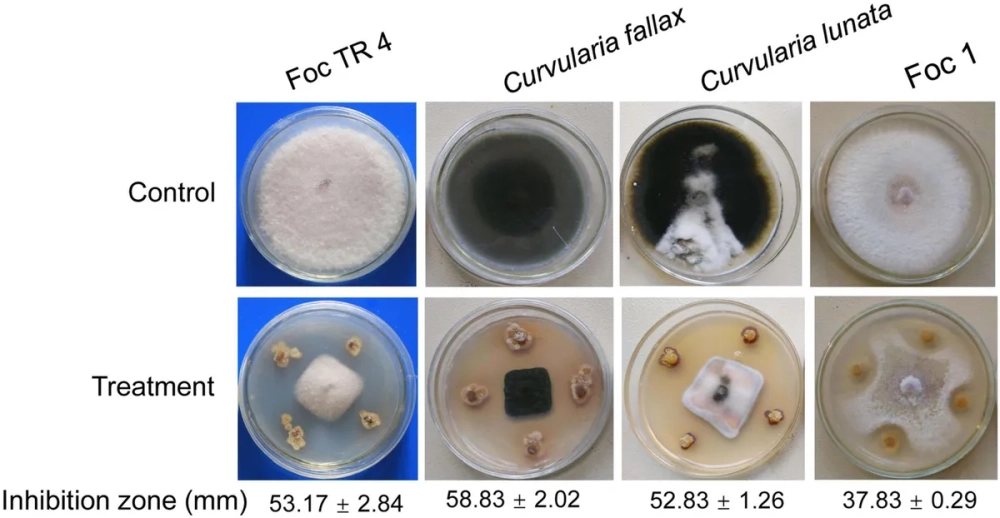
Sơ đồ cơ chế phát sinh đột biến điểm do tác nhân vật lý

Đột biến điểm là những biến đổi nhỏ xảy ra tại một điểm nhất định trên phân tử ADN. Việc hiểu rõ đột biến điểm là gì cùng các dạng đột biến điểm cơ bản sẽ giúp bạn nắm vững kiến thức về di truyền học và cơ chế phát sinh đột biến điểm trong tự nhiên.
Bản chất và các dạng đột biến điểm phổ biến trong sinh học
Đột biến điểm thực chất là một dạng của đột biến gen nhưng chỉ liên quan đến một cặp nucleotit. Các dạng đột biến điểm chính bao gồm đột biến thay thế cặp nucleotit, đột biến mất một cặp nucleotit và đột biến thêm một cặp nucleotit.
Trong đó, đột biến thay thế thường ít gây hậu quả nghiêm trọng hơn so với dạng thêm hoặc mất vì không làm thay đổi khung đọc mã di truyền.
Những biến đổi này có thể dẫn đến đột biến sai nghĩa, đột biến vô nghĩa hoặc đột biến đồng nghĩa tùy thuộc vào vị trí xảy ra.

Bộ sưu tập hình ảnh đột biến điểm và sơ đồ tư duy chi tiết
Bộ sưu tập này cung cấp cái nhìn trực quan về hậu quả của đột biến điểm, điển hình là bệnh thiếu máu hồng cầu hình liềm.
Bạn sẽ tìm thấy các ví dụ về đột biến điểm cụ thể, giúp so sánh đột biến điểm và đột biến gen một cách dễ dàng.
Ngoài ra, các sơ đồ tư duy đột biến điểm sẽ tóm tắt nguyên nhân gây đột biến điểm và giải thích đột biến điểm xảy ra ở đâu. Đây là tài liệu hỗ trợ đắc lực cho việc giải các bài tập trắc nghiệm đột biến điểm hiệu quả.
>>> Gợi ý cho bạn: Khám phá sơ đồ lai hai cặp tính trạng chi tiết và chuẩn xác

>>> Cùng tìm hiểu: Quy luật lai một cặp tính trạng và ứng dụng thực tiễn dễ hiểu
Hiểu rõ về đột biến điểm giúp chúng ta giải mã nhiều hiện tượng di truyền phức tạp. Để củng cố kiến thức, bạn hãy tham khảo thêm các bài viết về đột biến cấu trúc nhiễm sắc thể hoặc danh mục di truyền học phân tử trên website của chúng tôi nhé.
>>> Góc nhìn mới về: Giải mã bí ẩn di truyền học qua những khung hình sắc nét







